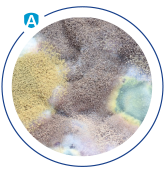
Neutralizacja alegrenów obraz 3

Domača uporaba

NEVTRALIZACIJA ALERGENOV
400 ml PRŠILO
Inovativna rešitev za nevtralizacijo alergenov v hišnem prahu. Zmanjšuje tveganja za razvoj alergij ali zmanjšuje njihove simptome. Pomaga pri zdravljenju simptomov alergij in astme.
- Nevtralizira glavne alergene prisotne v hišnem prahu.
- Učinkovitost do 6 mesecev po eni sami uporabi.
- Učinkovitost dokazana s testi.
- Varno in enostavno za uporabo.